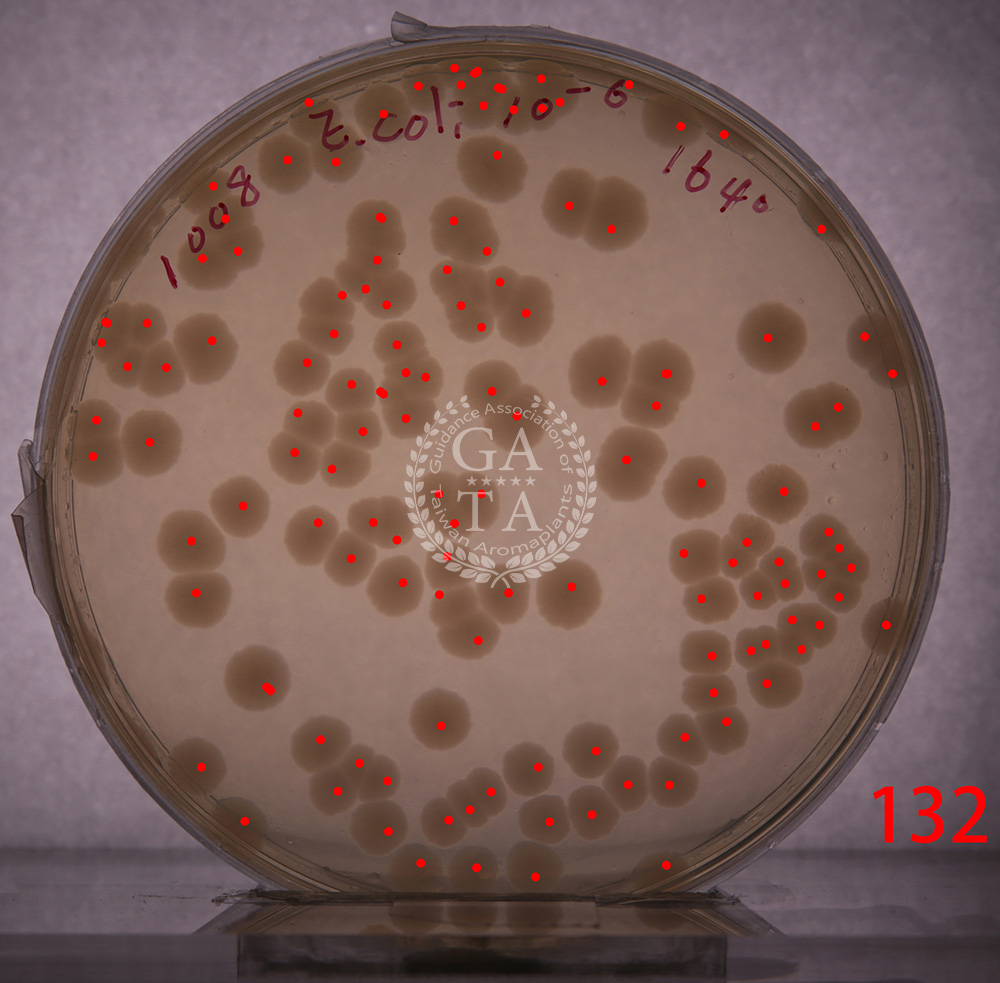

精油鑑定

成分分析實驗:Agilent Auto GC 氣相層析,能從 Kovats indices 及 Standard 內標外標比對 Aroma compounds data Base 算出芳香分子結構,每梯教材都會進行鑑定。GATA2畢業可安排來實驗室拍照。

細胞實驗:主要會分成動物細胞與人類來源細胞,會先找到芳香檢品的安全濃度,再後續觀察美白、抗皺、促黑、抗發炎等研究,細胞實驗也搭配生物分子蛋白表達靶點進行藥理研究。 |
微生物實驗:主要與抗感染有關,空氣中我們肉眼不可見這些微生物,有時與人體共存,有時做為致病菌危害人體,如何與微生物達到平衡是重要的課題。 |

抗氧化實驗:自由基因為本身不成對電子的特性,在人體中會抓細胞的電子,久而久之就加速人體老化,減少自由基簡易來說就是自由基變少,那老化就延緩。 |

